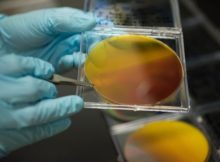

Author: MahmoudAyman
news
Cunning Idea needed – Make Time Travel Scientific Reality Introduction Literature professor Simon John James and physicist Richard Bower were each concerned in curating the exhibition, Time Machines – …
news
Robot completes 2-Hour Brain Surgery Procedure very fast Discussion Brain surgical procedure is precision commercial enterprise, and one slip can spell doom for affected patients. Even in one of …
news
California Grid Smashes Record Story behind On 13 May 2017, California smashed thru any other renewable power milestone as its biggest grid, managed with the aid of the California …
news
Chit – World’s First One-Bit Chemical Hard Drive Computing In classical computing, records is stored in bits which might be study via physical phenomena consisting of power. You would …
news
New Research Suggests Ancient Humans Helped Make World’s Largest Desert The desert existence It seems impossible to imagine. However where the Sahara is dominated nowadays with the aid of …
news
Reservoirs play substantial role regarding global warming Dam and reservoir. Not at all like regular water bodies, But reservoirs have a tendency to have overflowed lots of natural matter …
news
Life before oxygen Somewhere close to Earth’s creation and where we are today, researchers have exhibited that some early living things existed fine and dandy with no oxygen. While …
news
Are Smart Buildings Delivering on Their Promise to Reduce Energy Consumption? Buildings might move toward becoming “more brilliant,” yet that doesn’t really mean they’re sparing vitality. Truth be told, …
news
Teenager Just Built World’s Lightest Satellite Story An Indian young person has won an international competition to construct a functioning satellite, and not just has he delivered what is apparently …
news
Scientists May Be a Step Closer to Creating Solar-Fueled Vehicles Scientists are developing a realistic method to transform water and sunshine into gasoline — a key step in in …